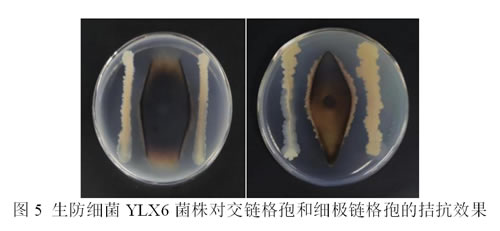
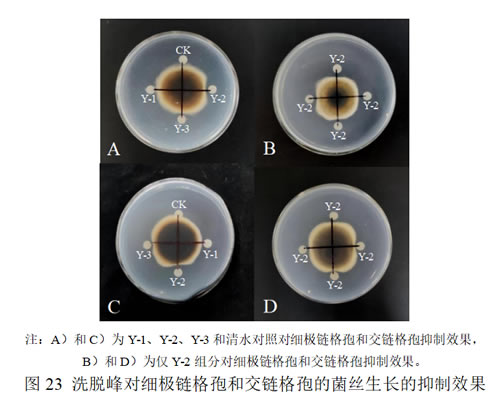

蓝靛果哈尔滨
霍俊伟 李永刚
蓝靛果(学名:蓝果忍冬,Lonicera caerulea L.)作为忍冬科忍冬属多年生灌木果树,其浆果富含花青素、氨基酸、黄酮醇等生理活性物质,兼具高经济价值与营养保健功能,是我国北方寒地特色果树产业的核心品种之一。截至 2024 年初,黑龙江省蓝靛果栽培面积已突破 2000 hm²,但随着种植规模扩大,病害问题日益凸显,其中链格孢叶斑病危害最为严重。该病导致叶片出现不规则棕褐色病斑,后期病斑融合、叶片枯萎脱落,严重时可使果实产量下降 30% 以上,品质(如可溶性固形物含量、果实硬度)显著降低,成为制约蓝靛果产业高质量发展的关键瓶颈。
目前,蓝靛果叶斑病防治仍依赖化学药剂,但长期使用易导致病原菌抗药性、果实农药残留等问题,与 “绿色轻简化栽培” 理念相悖。生物防治因环境友好、可持续性强等优势,成为近年来研究热点。本研究系统开展蓝靛果链格孢叶斑病病原菌鉴定、生防菌筛选与应用、杀菌剂筛选及抗病资源评估,旨在构建 “生物防治为主、化学防治为辅” 的综合防控体系,为蓝靛果产业健康发展提供技术支撑。
1. 材料与方法
1.1 试验材料
1.1.1 供试蓝靛果品种与地块
试材为黑龙江省主栽蓝靛果品种‘蓝精灵’‘日 M-3’‘奇卡 3’等 30 份种质资源,树龄 6 年生(扦插苗),定植于东北农业大学向阳基地蓝靛果种质资源圃(E126°43.57′,N45°44.23′)。试验地块土壤类型为黑壤土,有机质含量 11.91 g・kg⁻¹,全氮 1.96 g・kg⁻¹,pH 6.33,田间管理方式为人工精细化管理,行间覆防草布,无灌溉系统。
1.1.2 病原菌与培养基
(1)病原菌:从田间发病叶片中分离纯化的链格孢属菌株,经形态学与分子生物学鉴定为细极链格孢(Alternaria tenuissima)和交链格孢(A. alternata)。
(2)PDA 培养基(马铃薯葡萄糖琼脂):用于病原菌培养与对峙试验,配方为马铃薯 200 g、葡萄糖 20 g、琼脂 18 g、蒸馏水 1000 mL(pH 7.0-7.2)。
(3)LB 培养基(营养肉汤):用于生防菌培养,配方为酵母提取物 5 g、蛋白胨 10 g、NaCl 10 g、蒸馏水 1000 mL(pH 7.0-7.2)。
(4)产脂肽发酵培养基:用于生防菌脂肽类物质提取,配方为蔗糖 200 g、酵母膏 0.2 g、Na₂HPO₄ 10 g、MgSO₄・7H₂O 0.2 g、NH₄NO₃ 2 g、蒸馏水 1000 mL。
1.1.3 供试药剂
化学杀菌剂:30% 吡唑醚菌酯悬浮剂、0.8% 大黄素甲醚悬浮剂、0.5% 小檗碱水剂;生防菌剂:枯草芽孢杆菌(Bacillus subtilis)YLX6 发酵液(浓度 1×10⁸ cfu/mL)及其脂肽类提取物(纯度≥90%)。
1.2 试验设计
1.2.1 病原菌鉴定试验
采用组织分离法分离病原菌:选取典型病叶,在病健交界处剪取 5×5 mm 组织块,经 75% 酒精消毒 10 s、2% 次氯酸钠浸泡 5 min 后,无菌水冲洗 3 次,接种于 PDA 平板,25℃培养 5 d,纯化后通过柯赫氏法则验证致病性;结合形态学观察(菌落颜色、分生孢子形态)与分子生物学鉴定(ITS、GAPDH、EF1-α、HIS 3 基因扩增与测序)确定病原菌种类。
1.2.2 生防菌筛选与鉴定试验
生防菌分离:从健康蓝靛果叶片中分离内生细菌,采用稀释平板法(稀释梯度 10⁻²-10⁻⁵)涂布 LB 平板,28℃培养 3 d,纯化后保存。
生防菌初筛:以细极链格孢和交链格孢为靶标病原菌,采用平板对峙法,在 PDA 平板距中心 3 cm 处划线接种生防菌,中心接种病原菌菌碟(直径 0.7 cm),25℃培养 5 d,筛选 “最长半径 / 最短半径>2” 的菌株。
生防菌鉴定:通过形态学观察(菌落形态、革兰氏染色)、生理生化试验(硝酸盐还原、糖发酵等)及 16S rDNA 基因测序确定菌株分类地位。
1.2.3 生防菌抑菌机制与稳定性试验
脂肽类提取物制备:生防菌发酵液经离心(4℃、10000 rpm、20 min)取上清,6M HCl 调 pH 至 2.0 沉淀过夜,甲醇提取后旋转蒸发浓缩。
抑菌机制测定:设置脂肽浓度 1、5、10 μL/mL,测定对病原菌分生孢子萌发、菌丝生长的抑制率,光学显微镜观察菌丝形态变化。
稳定性测定:分别通过不同温度(4℃、20℃、40℃、60℃、80℃、100℃、121℃)、pH(2.0-12.0)、紫外照射时间(30、60、90 min)处理脂肽提取物,测定抑菌活性变化。
1.2.4 杀菌剂敏感性与田间防效试验
室内敏感性测定:采用菌丝生长速率法,将杀菌剂梯度稀释(吡唑醚菌酯 0.001-0.02 mg/L、小檗碱 0.005-15.0 mg/L)加入 PDA 培养基,接种病原菌菌碟,25℃培养 5 d,计算 EC₅₀。
田间防效试验:设 6 个处理,每个处理 3 次重复,小区面积 20 m²,采用大疆 T10 植保无人机叶面喷施,发病初期施药,间隔 7-10 d,共施药 3 次,末次施药后 14 d 调查病情指数与防效。
1.2.5 抗病资源评估试验
在田间自然发病高峰期,对 30 份蓝靛果种质资源进行抗性调查,每品种随机选 3 株,每株调查 4 个方向 10 片叶片,按病斑面积分级(0 级:无病斑;1 级:病斑<25%;2 级:25%-50%;3 级:51%-75%;4 级:>75%),计算病情指数(DI),划分抗性等级(高抗 HR:DI 0-5;抗病 R:6-15;感病 S:16-25;高感 HS:>25)。
1.3 测定指标与方法
1.3.1 病原菌分离频率
分离频率(%)= 某病原菌分离株数 / 总分离株数 × 100%。
1.3.2 生防菌促生能力
产 IAA 能力:采用 Salkowski 比色法,测定 530 nm 吸光值,结合标准曲线计算 IAA 产量。
产 ACC 脱氨酶能力:接种生防菌于 ADF 培养基(ACC 为唯一氮源),测定 600 nm 吸光值(OD₆₀₀>0.1 为阳性)。
生物膜形成能力:采用结晶紫染色法,96 孔板培养 48 h 后,乙醇脱色,测定 590 nm 吸光值。
1.3.3 病情指数与防效
病情指数(DI)= 100×∑(病叶数 × 对应级数)/(总叶数 × 最高级数)
防治效果(%)=(对照 DI - 处理 DI)/ 对照 DI × 100%
1.3.4 数据分析
采用 Microsoft Excel 2019 整理数据,IBM SPSS Statistics 25 进行差异显著性分析(P<0.05 为显著),MEGA 7.0 构建系统发育树。
2 结果与分析
2.1 蓝靛果叶斑病病原菌的分离和鉴定
2.1.1 蓝靛果叶斑病病原物的分离和致病力测定
在黑龙江省东北农业大学向阳农场的小浆果种植基地中发现一种蓝靛果叶斑病,初期症状为小的棕色和不规则的病斑,沿着叶片边缘呈不规则的斑点扩大;在严重的情况下,受侵染的叶片逐渐卷曲、枯萎并从植株上脱落(见图1)。

采用组织分离法获得形态学基本一致的真菌分离物64株,于PDA培养基扩繁后,将孢子悬浮液滴加至叶片上完成病原菌接种,进行柯赫氏法则验证。结果显示,所有接种的蓝靛果叶片均发病,并且与田间发病症状基本一致,对照组未发病;从接种发病的叶片上再次分离纯化所得的全部真菌分离物与用于接种的病原真菌形态学完全一致。因此,可以确定所获得的分离物正是引起蓝靛果叶斑病的致病因子。
2.1.2 形态学鉴定
将分离和致病力测定后的的蓝靛果叶斑病菌于25℃培养5 d。
在PDA培养基上,菌落呈橄榄绿,边缘白色,并富含气生菌丝。分生孢子梗以长链和不分枝链的形式产生。分生孢子颜色为棕色,斜弯,有1-6个横向隔膜和0-2个纵向隔膜,大小为13.4-34.2 μm × 7.5-11.8 μm(图2)。根据形态特征,这些菌株初步被鉴定细极链格孢(Alternaria tenuissima)。
在PDA培养基上,菌落呈橄榄绿,菌落底部有白色边缘和黑色色素,有丰富的絮状气生菌丝。分生孢子呈卵圆形或椭圆形,棕色至浅棕色,短喙,通常呈链状,有2-5个横向隔膜,0-3个纵向或斜隔膜,大小为8.27-15.31 μm × 17.51-24.31 μm(图2)。根据形态特征,这些菌株初步被鉴定交链格孢(A. alternata)。

2.1.3 病原菌分子鉴定
初步鉴定为细极链格孢(A. tenuissima)菌株选取LDG2为代表性菌株进行分子生物学鉴定。将代表菌株LDG2的四个真菌通用引物(ITS、EF1-a、GAPDG和HIS 3)的DNA序列提交给GenBank(http://www.ncbi.nlm.nih.gov),ITS、EF1-a、GAPDG和HIS 3的登录号分别为PP412068、PP417745、PP417744和PP539905。BLASTN分析发现,获得的ITS、EF1-a、GAPDG和HIS 3区域的序列与细极链格孢(A. tenuissima)相似度最高。使用邻接法(NJ)对四个基因的串联序列进行系统发育分析,代表性菌株LDG2与细极链格孢A. tenuissima isolate DD-ZX-TSC1(OQ026922.1,ITS)、isolate SY-1(OP980552.1,EF-1α)、isolate NCBC-3-2-2-1(OR485367.1,GAPDH)和isolate BA2(MH191343.1,HIS 3)归于同一进化枝,且相似性高达100%,亲缘关系极近,同为细极链格孢(见图3)。
初步鉴定为交链格孢(A. alternata)菌株选取LDG7为代表性菌株进行分子生物学鉴定。将代表菌株LDG7的四个真菌通用引物(ITS、EF1-a、GAPDG和HIS 3)的DNA序列提交给GenBank(http://www.ncbi.nlm.nih.gov),ITS、EF1-a、GAPDG和HIS 3的登录号分别为PP407345、PP417746、PP359582和PP539904。BLASTN分析发现,获得的ITS、EF1-a、GAPDG和HIS 3区域的序列与交链格孢(A. alternata)相似度最高。使用邻接法(NJ)对四个基因的串联序列进行系统发育分析,代表性菌株LDG7与交链格孢 A. alternata strain PaF-3(MN646267.1,ITS)、isolate HY2-6(OR419797.1,EF-1α)、strain PaF-3(MN657411.1,GAPDH)和isolate NCBC-9-1-2-2(OR485381.1,HIS 3)归于同一进化枝,且相似性高达92%,亲缘关系极近,同为交链格孢(见图4)。

2.1.4 蓝靛果叶斑病病原菌分离频率
综上所述,依据形态学、分子生物学鉴定及系统发育树分析,上述引起蓝靛果叶斑病病原菌为细极链格孢(A. tenuissima)和交链格孢(A. alternata)两种病原物。从表1可以看出,细极链格孢和交链格孢的分离比为46:18,也就是说细极链格孢是引发蓝靛果叶斑病的优势种群。

2.2 蓝靛果链格孢叶斑病生防菌的筛选鉴定与应用研究
2.2.1 生防菌的筛选
采用平板对峙法,本论文对从蓝靛果叶片中获得的120株内生细菌菌株筛选出1株生防细菌(命名为YLX6),对蓝靛果叶斑病菌细极链格孢和交链格孢的拮抗作用较好,最长半径/最短半径均大于2,具有良好的生物防治潜力,用于下一步试验。
2.2.2 生防菌YLX6的鉴定
2.2.2.1 形态学鉴定
生防菌YLX6在LB固体培养基上培养28℃培养3 d后,菌落呈乳白色,形状为边缘不整齐的圆形,中央隆起,表面褶皱,有粘性,能形成芽孢,菌体为杆状。

2.2.2.2 生理生化鉴定
菌株YLX6生理生化特性测定结果如表2、图7和图8所示,YLX6为革兰氏阳性细菌,能产生硝酸盐还原酶,不能产生硫化氢。能利用麦芽糖、葡萄糖、甘露醇、果糖,不能利用木糖、肌醇、乳糖和鼠李糖。能水解明胶;丙二酸盐试验阴性;西蒙式柠檬酸盐和V-P试验阳性。

2.2.2.3 分子生物学鉴定
生防菌YLX6的PCR产物扩增和测序后得到长度为1429 bp的16S rDNA的产物。在NCBI上进行BLASTN比对,生防菌YLX6与菌株Bacillus subtilis HSY21(登录号为MT513998.1)的相似度高达为100%,上传GeneBank获得菌株登录号为OR226588.1。使用MEGA软件进行系统发育树分析,结果如图9所示,生防菌株YLX6与B. subtilis strain HSY21(MT513998.1)归于同一进化枝,相似性达98%,亲缘关系极近,同为枯草芽孢杆菌。
综上所述,基于形态学鉴定、生理特征和生化反应分析以及分子生物学鉴定,结合系统发育树分析,最终确定生防菌YLX6为枯草芽孢杆菌(B. subtilis)。

2.2.3 生防菌YLX6对八种叶斑病菌的拮抗作用
为明确筛选到的生防细菌YLX6对其它作物叶斑病病原真菌的拮抗效果,对本课题组保存的8种作物的叶斑病病原菌进行拮抗作用的测定,从表3和图10可以发现,生防菌YLX6对多种叶斑病害病原真菌均具有一定的抑制作用,特别是对绿苏叶斑病菌(Cytospora chrysosperma)的抑菌效果最好,最长半径比最短半径为2.56,其次是猕猴桃叶斑病菌(Neopestalotiopsis rosae)和蛇莓叶斑病菌(Diaporthe eres)。上述结果表明,生防菌YLX6有较广的抑菌谱,其在叶斑类病害的生物防治上展示出良好的潜力。

2.2.4 生防菌YLX6的促生和定殖能力
2.2.4.1 生防菌YLX6产吲哚乙酸(IAA)能力
采用Salkowski比色法在OD530值下测定菌株产IAA能力,从图11可以看出,加入色氨酸的处理呈微红色,不加色氨酸的对照组呈淡黄色,由此可以判断菌株YLX6具有利用前体物质色氨酸合成IAA的能力。IAA溶液浓度与OD530有良好的线性关系,其回归方程为:Y=0.0185X+0.0048,相关系数为0.9934,用紫外分光光度计在530 nm下测定吸光值为0.56,代入回归方程计算出该菌株IAA的产量为0.015 mg/L。

2.2.4.2 生防菌YLX6产ACC脱氨酶能力
对生防菌YLX6的ACC脱氨酶能力测定结果显示,转接后的YLX6菌液在紫外分光光度计600 nm下的吸光值为0.30,大于0.1,而阴性对照的吸光值为0.02(小于0.1),说明生防菌YLX6能够利用ACC为唯一氮源生长,具有产ACC脱氨酶的能力。
综上所述,通过对生防菌YLX6产吲哚乙酸(IAA)和ACC脱氨酶能力的检测,其间接展示了良好的促生能力。
2.2.4.3 生防菌YLX6的生物膜形成能力
如图12所示,生防菌株YLX6的96孔板壁上可以明显观察到紫色环痕,说明该生防菌株可以产生生物膜,经酶标仪测定的OD590值为3.565,间接表明生防菌株YLX6具有良好的定殖能力。

2.2.5 生防菌YLX6抑菌机理及活性物质稳定性
2.2.5.1 生防菌YLX6脂肽类提取物的抑菌机制
(1)脂肽类提取物对蓝靛果链格孢叶斑病菌的作用机制
从生防菌YLX6的脂肽类提取物对蓝靛果叶斑病菌细极链格孢和交链格孢的影响可以看出,不同浓度处理对两种病原菌的分生孢子萌发、产生和菌丝生长都有显著抑制作用,且随着脂肽类纯化物质浓度的增加,抑制作用也越加明显。当浓度为10 μL/mL时,脂肽类提取物对细极链格孢的分生孢子萌发、分生孢子产生和菌丝生长的抑制率分别为55.9%、79.7%和60.0%,对交链格孢的分生孢子萌发、分生孢子产生和菌丝生长的抑制率分别为61.5%、77.0%和50.8%。


(2)生防菌YLX6脂肽类物质对蓝靛果叶斑病菌菌丝形态的影响
正常培养且未经YLX6脂肽类物质浸泡过的菌丝,生长点均匀、纤细,菌丝表面光滑,在测定的时间内不产生厚垣孢子。而从图17可以看出,经不同浓度的YLX6脂肽类物质处理后,细极链格孢菌丝出现不同程度的菌丝畸形扭曲,菌丝上部分膨大形成大量厚垣孢子。
从图18可以看出,脂肽类物质的处理严重影响交链格孢的菌丝形态,其菌丝发生了严重的扭曲、折叠,部分菌丝发生断裂,胞质外泄,有厚垣孢子形成。随着YLX6脂肽类物质处理浓度的增加,菌丝的各项变化越明显。

2.2.5.2 生防菌YLX6脂肽类提取物的稳定性测定
(1)温度对生防菌YLX6脂肽类抑菌活性成分的影响
对YLX6脂肽类提取物的温度稳定性测定结果表明,经4℃~121℃不同温度处理过后,其抑菌活性并没有非常明显的下降趋势(如图19),可以看出该脂肽类物质在较高温度下仍能保持较高的抑菌水平,具有较好的稳定性。

(2)pH对生防菌YLX6脂肽类抑菌活性成分的影响
对YLX6脂肽类提取物的酸碱稳定性测定结果表明,未进行酸碱处理的(pH为8)脂肽物质抑菌效果最佳,对细极链格孢和交链格孢抑菌率分别为为55.8%和55.2%;当pH为3-7和9-11时,抑菌活性有所下降,但抑菌率整体高于45%;当pH为2和12时,抑菌率明显下降,但并未完全丧失,说明该脂肽类物质对酸碱变化较为耐受,但不耐强酸强碱环境。

(3)紫外线对生防菌YLX6脂肽类抑菌活性成分的影响
从图21可以看出,紫外照射30 min、60 min和90 min对生防菌YLX6脂肽类抑菌活性成分影响较小,说明YLX6脂肽类抑菌活性成分对紫外线不敏感。

2.2.6 生防菌YLX6脂肽类抑菌活性成分的纯化与鉴定
2.2.6.1 纯化
生防细菌YLX6的脂肽类提取物在200 nm至1100 nm之间全波长扫描,扫描结果显示:脂肽粗提物最高的吸收峰出现在215 nm处。因此,选用215 nm波长进行蛋白纯化分析步骤。经过分子筛按质量大小洗脱得到70-73管、77-78管和79管3组洗脱峰,依次命名为Y-1、Y-2和Y-3(图22)。

2.2.6.2 生防菌YLX6脂肽类提取物三个洗脱峰抑菌活性的测定
采用对峙培养法测定三组洗脱峰的抑菌活性,结果如图23所示,Y-2组洗脱峰对两种链格孢菌菌丝的拮抗效果均最好;而Y-3有一定效果,可能是因连峰原因;Y-1洗脱峰无抑制效果,故将第二组洗脱峰保留用于进一步分析。
2.2.6.3 质谱分析鉴定
采用基质辅助激光解吸电离飞行时间质谱仪,对YLX6脂肽类物质纯化后获得的Y-2洗脱峰进行鉴定。从图24可以看出,在m/z 1008、1022和1036处有[(M+H)+]分子离子峰,且相差14 Da,即相差一个-CH2的分子量大小,分别与已知的C13-Surfactin、C14-Surfactin、C15 Surfactin分子量相同;在m/z 1043和1057处有[(M+H)+]分子离子峰,且这两种物质的分子量相差14 Da,分别与已知的C14-Iturin A和C15-Iturin A分子量相同。
综上所述,推测枯草芽孢杆菌YLX6脂肽类抑菌活性成分主要为表面活性素和伊枯草菌素A。

2.3 蓝靛果链格孢叶斑病的防治方法的探索
2.3.1 蓝靛果链格孢叶斑病抗病资源的评估
采用田间病谱种植后自然发病的鉴定方法,对30份品种和育种材料进行了抗病性评价,结果表明:30份材料中1份为感病(日M-3);29份为高感,包括L5、A5、A3、A4、A2、A1、VRK16、RB、密1、14-14-8、H2012-2、H2012-6、俄1号、14-14-1、14-13-4、MC-5、BJ2、CBS-5、L4、05-104、15-4-1、16-1-2、MC-1、05-14、奇卡3、蓝精灵、ZQR、H2012-5和MC-2。从上述结果可以看出,未发现抗病资源,培育和选用抗病品种防治该病害仍需要较长的时间和大量的筛选工作。

2.3.2 杀菌剂及脂肽类提取物敏感性测定
由表7可以看出,供试药剂对细极链格孢菌株均有一定的抑制效果,但各药剂间差异明显。其中,小檗碱EC50最低,仅为0.0125 μg/mL,这表明细极链格孢对小檗碱呈现出较高的敏感性,在较低的浓度条件下亦能产生强烈的抑制效果;而脂肽类提取物EC50最高,达到了7.7900 μg/mL。
由表8可知:供试药剂对交链格孢菌株均有一定的抑制效果,其中,吡唑醚菌酯EC50最低,仅为0.0055 μg/mL,脂肽类提取物EC50最高,达到了9.1160 μg/mL。
综上所述,两种病原菌对杀菌剂吡唑醚菌酯、小檗碱和大黄素甲醚均表现出一定的敏感性,可以进行田间防效的进一步筛选。

2.3.3 蓝靛果链格孢叶斑病的田间防治
通过对不同处理蓝靛果叶斑病发生情况调查,结果表明,吡唑醚菌酯、小檗碱和生防菌发酵液对该病防治效果较好,防效分别为79.0%、64.9%和65.0%,脂肽类提取物和大黄素甲醚对蓝靛果叶斑病的防治效果稍弱,防效分别为58.1%和58.2%。综上所述,这5个处理均能有效控制蓝靛果叶斑病的发生与发展,其中优先考虑吡唑醚菌酯,其次为小檗碱和大黄素甲醚,也可交替使用防止病原菌产生抗药性。生防菌YLX6菌悬液和脂肽类提取物也展示了较好的防治效果,为该菌株的开发与利用奠定了坚实的基础。

综上所述,蓝靛果生产上的主要品种和育种资源均不抗链格孢叶斑病,蓝靛果链格孢叶斑病可以通过化学和生物杀菌剂吡唑醚菌酯、小檗碱和大黄素甲醚实现有效控制。利用本研究筛选和鉴定的生防芽孢杆菌也展示较好的生防潜力,为该病害的生物防治奠定了坚实的基础。
3. 讨论与结论
3.1 讨论
3.1.1 病原菌优势种与危害特性
本研究明确细极链格孢为蓝靛果链格孢叶斑病的优势菌株,该病原菌寄主范围广,可通过风雨传播,在 20-29℃、湿度>85% 条件下快速侵染,导致叶片早落,影响光合作用与果实发育。因此,防控需重点针对细极链格孢,兼顾交链格孢。
3.1.2 生防菌 YLX6 的应用潜力
枯草芽孢杆菌 YLX6 通过产生表面活性素和伊枯草菌素 A 抑制病原菌,兼具促生(产 IAA、ACC 脱氨酶)与定殖(生物膜形成)能力,且脂肽类物质耐高低温、抗紫外,适合北方寒地复杂气候。田间试验显示其发酵液防效达 65.0%,与小檗碱相当,可替代部分化学药剂,减少农药残留。
3.1.3 综合防控策略的必要性
当前蓝靛果种质资源无抗病材料,化学防治仍是应急防控的关键。吡唑醚菌酯对两种病原菌防效最优,但长期使用易产生抗药性,建议与小檗碱、生防菌交替使用。生防菌 YLX6 脂肽提取物防效稍低,但环境友好,可用于绿色生产基地或采前 15-20 d 喷施,降低果实农药残留。
3.2 结论
(1)病原菌鉴定:蓝靛果链格孢叶斑病由细极链格孢(优势种,分离频率 71.9%)和交链格孢引起,需针对性防控。
(2)生防菌应用:枯草芽孢杆菌 YLX6 可通过叶片喷施(浓度 1×10⁸ cfu/mL)防控病害,间隔 7-10 d,连续喷施 3 次,防效达 65.0%;其脂肽提取物(10 μL/mL)可用于精准防控,适合绿色生产。
(3)化学防治推荐:优先选用 30% 吡唑醚菌酯悬浮剂(8 mL / 亩)或 0.5% 小檗碱水剂(200 mL / 亩),发病初期喷施,间隔 7-10 d,连续 2-3 次,避免单一药剂长期使用。
(4)抗病育种方向:现有品种抗性差,需加快抗病种质资源筛选与杂交育种,培育抗链格孢叶斑病的蓝靛果新品种。
3.3 技术应用建议
(1)喷施时机:避开高温(10:00-15:00)与降雨时段,选择傍晚或阴天喷施,确保药剂附着与吸收。
(2)药剂配制:生防菌发酵液与脂肽提取物现配现用,避免与强酸强碱农药混用;化学药剂严格按稀释倍数配制,防止药害。
(3)绿色生产搭配:绿色基地可采用 “YLX6 发酵液(第 1 次)+ 小檗碱(第 2 次)” 交替喷施,采前 20 d 停用化学药剂,仅喷施 YLX6 脂肽提取物。
(4)田间辅助措施:及时清除病叶、落叶,减少病原菌越冬基数;增施有机肥,提高植株抗病性。